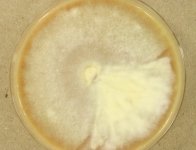

Search Details
| UAMH Number: | 3754 |
|---|---|
| Species Name: | Trichophyton rubrum |
| Type: | Trichophyton fischeri |
| Synonyms: | Aleurosporia rosacea / Ectotrichophyton kagawaense / Ectotrichophyton megninii / Ectotrichophyton multicolor / Ectotrichophyton vinosum / Epidermophyton floccosum var. pernettii / Epidermophyton lanoroseum / Epidermophyton pedis / Epidermophyton pernettii / Epidermophyton plurizoniforme / Epidermophyton purpureum / Epidermophyton rubidum / Epidermophyton rubrum / Favotrichophyton coccineum / Kaufmannwolfia pedis / Megatrichophyton megninii / Megatrichophyton roseum / Megatrichophyton roseum var. vinosum / Megatrichophyton vinosum / Sabouraudiella purpurea / Sabouraudiella rubra / Sabouraudites lanoroseus / Sabouraudites plurizoniformis / Sabouraudites ruber / Trichophyton circonvolutum / Trichophyton coccineum / Trichophyton fischeri / Trichophyton fluviomuniense / Trichophyton gourvilii var. intermedium / Trichophyton kagawaense / Trichophyton kanei / Trichophyton kuryangei / Trichophyton marginatum / Trichophyton megninii / Trichophyton multicolor / Trichophyton olexae / Trichophyton pedis / Trichophyton pervesi / Trichophyton pervesii / Trichophyton plurizoniforme / Trichophyton purpureum / Trichophyton raubitschekii / Trichophyton rodhaini / Trichophyton rodhainii / Trichophyton rosacea / Trichophyton rosaceum / Trichophyton roseum / Trichophyton rubidum / Trichophyton rubrum var. nigricans / Trichophyton rubrum var. rodhainii / Trichophyton vinosum |
| Taxonomy: | FUNGI Ascomycota, Eurotiomycetes, Onygenales, Arthrodermataceae |
| Strain History: | CDC B-2095 -> UAMH |
| Substrate: | feline ringworm | Location: | UNKNOWN (GEO: ?,?) |
| Isolator: | |
| Isolation Date: | |
| Date Received: | 1975-01-03 |
| Characters: | MOLECULAR SYSTEMATICS phylogeny of onygenalean fungi - Untereiner, Scott, Naveau, Currah & Bachewich, Stud. Mycol. 47:25-35, 2002 // MOLECULAR SYSTEMATICS Whole genome sequence available - (Click for publications citing UAMH 3754) |
| Compounds: | |
| Cross Reference: | ATCC 28328 // ATCC 32871 // CBS 100081 // CDC B-2095 // IMI 197520 // IMI 213848 // MUCL 39756 // SF 5110 // VUT-74039 |
| Collections: | Living Strains; Dried Herbarium Material |
| Pathogenic Potential: | Human: yes | Animal: yes | Plant: no |
| Biosafety Risk Group: | RG2 (check the PHAC ePATHogen Risk Group Database for updates) |
| Regulatory Requirements: | Canadian requesters must provide PHAC Pathogen and Toxin License Number (see: https://www.canada.ca/en/public-health/services/laboratory-biosafety-biosecurity/licensing-program.html) prior to shipment. International requesters must provide all legally required importation documentation prior to shipment. Plant pathogenicity status may be verified by using the USDA Agricultural Research Service (ARS) Fungal Database |
| MycoBank ID: | 254498 |
| Sequences: | >UAMH03754_AJ270792_ITS TTAGAGGAAGTAAGAGTCGTAACAAGGTTTCCGTAGTGAACCTGCGGAAGGATCATTAACGCGCAGGCCGGAGGTGGCCCCCCACGATAGGGACCGACGTTCCATCAGGGGTGAGCAGACGTGCGCCGGCCGTACGCCCCCATTCTTGTCTACCTCACCCGGTTGCCTCGGCGGGCCGCGCTCCCCCTGCCAGGGAGAGCCGTCCGGCGGGCCCCTTCTGGGAGCCTCGAGCCGGACCGCGCCCGCCGGAGGACAGACACCAAGAAAAAATTCTCTGAAGAGCTGTCAGTCTGAGCGTTTAGCAAGCACAATCAGTTAAAACTTTCAACAACGGATCTCTTGGTTCCGGCATCGATGAAGAACGCAGCGAAATGCGATAAGTAATGTGAATTGCAGAATTCCGTGAATCATCGAATCTTTGAACGCACATTGCGCCCTCTGGCATTCCGGGGGGCATGCCTGTTCGAGCGTCATTTCAACCCCTCAAGCCCGGCTTGTGTGATGGACGACCGTCCGGCCCCTCCCTTCGGGGGCGGGACGCGCCCGAAAAGCAGTGGCCAGGCCGCGATTCCGGCTTCCTAGGCGAATGGGCAGCCAATTCAGCGCCCTCAGGACCGGCCGCCCTGGCCCCAATCTTTATATATATATATATCTTTTCAGGTTGACCTCGGATCAGGTAGGGATACCCGCTGAACTTAAGCATATCAATAAGCGGAGGAA >UAMH03754_AY176739_LSU GAAACCAACAGGGATTGCCCCAGTAACGGCGAGTGAAGCGGCAAGAGCTCAAATTTGAAATCTGGCCTCCCTTGGGGGGTCCGAGTTGTAATTTGTAGAGGATGCTTCGGGTGTGGCCGCCGTCTAAGTTCCTTGGAACAGGACGTCGTAGAGGGTGAGAATCCCGTCTTGGGCGGCCGGTCCGCGCCCGTGTGAAGCTCCTTCGACGAGTCGAGTTGTTTGGGAATGCAGCTCTAAGCGGGTGGTAAATTTCATCTAAAGCTAAATACTGGCCGGAGACCGATAGCGCACAAGTAGAGTGATCGAAAGGTTAAAAGCACCTTGAAAAGGGAGTTAAACAGCACGTGAAATTGTTGAAAGGGAAGCGCTTGCGGCCAGACTCGAGGGGCGGGGTTCAGCGGGTGCGCGTCACCCGTGCACTCCCCGTCCCCCCGGGCCAGCATCAGTTTCGACGGCCGGTCAAAGGCCCCCGGAATGTGTCGTCTCTAGGGACGTCTTATAGCCGGGGGTGCAATGCGGCCCGCCGGGACTGAGGAACGCGCTCCGGCTCGGATGCTGGCGTAATGGCCGTAAGCGGCCCGTCTTGAAACACGGACCAAGGAGTCTAACATCCACGCGAGTGTTCGGGTGTCAAACCCGTGCGCGCAGTGAAAGCGAACGGAGGTGGGAGCCCTAGGGCGCACCATCGACCGATCCTGAAGTCTTCGGATGGATTTGAGTAGGAGCGTGGCCGTTGGGACCCGAAAGATGGTGAACTATGCCTGAATAGGGTGAAGCCAGAGGAAACTCTGGTGGAGGCTCGCAGCGGTTCTGACGTGCAAATCGATCGTCAAATTTGGGCATAGGGGCGAAAGACTAATCGAACCATCTAGTAGCTGGTTCCTGCCGAAGTTTCCCTCAGGATAGCAGTGACGAGATTCCAGTTTTATGAGGTAAAGCGAATGATTA |
IMAGES: